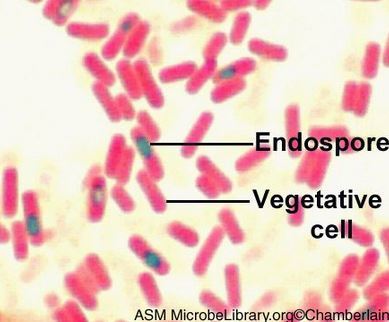

smear
A thin film of material containing microorganisms spread over the surface of a clean microscope slide;Good for discerning (1) the morphology of cells such as rods, cocci, and other bacterial shapes; (2) the arrangement of cells, such as single cells, chains, or clusters; and (3) internal structures, such as endospores and cell inclusions
negative staining
Stains that are acidic and thus have a negatively charged chromophore that does not penetrate the cell but rater is repelled by the similarly charged bacterial cell; stains background; useful in studying the morphology of bacterial cells and characterizing some of the external structures, such as capsules, that are associated with bacterial cells; heat fixation is avoided to avoid shrinking the structures

capsule
extracellular gel-like layer (distinct and gelatinous) that occurs outside of the cell
protective structures because they prevent phagocytic white blood cells from engulfing and destroying the pathogen
allows attachment of organisms to solid surfaces in environment
slime layer
extracellular gel-like layer (diffuse and irregular) that occurs outside of the cell
glycocalyx
external layer made up of polysaccharides (‘sugar shell’)
capsular staining (Anthony method)
smears are prepared from cultures in grown in skim milk broth and air dried (bot not heat fixed); Stained with crystal violet for 2 minutes which binds cell and milk culture (background of plate) which causes capsule to appear white

Gram stain
Differential stain that differentiates from gram-positive cells and gram-negative cells
primary stain
initially stains both gram-positive and gram-negative cells (crystal violet)
mordant
forms an insoluble complex in gram-positive cells with primary stain (iodine)
decolorization
Removes the dye-mordant complex from gram-negative cells, leaving them colorless (ethyl alcohol)
peptidoglycan
Makes up the bacteria cell wall
composed of unique complex carbohydrate and protein
counterstain
Recolorizes the gram-negative cells (safarin)
gram-negative
Possesses a thin layer of peptidoglycan between a cell membrane and outer membrane

gram-positive
Possesses a thick layer of peptidoglycan and a cell membrane; no outer membrane

endospores
structure to survive harsh environmental conditions (exhaust essential nutrients); a dormant cell stage;
resistant to heat, drying, and numerous chemicals
hard outer covering of bacteria to protect themselves while dormant
when nutrients become available it goes through germination to form a new vegetative cell
autoclave
steam under pressure. kills all organisms and endospores. steam must contact items surface
spore staining (Shaeffer-Fulton)
Heat is applied while staining with malachite green, which penetrates the cell and becomes trapped in the endospore; safranin stains the vegetative portion of the cell
acid-fast staining (Ziehl-Neelsen)
Phenol and heat facilitate the penetration of the carbolfuchsin into the cell (heat acts as a mordant to make the mycolic acid and cell wall lipids more permeable to the stain); subsequent treatment of the cells with acid-alcohol, a decolorizer, does not remove the entrapped stain from cells; methylene blue is used as counter stain to visualize non acid-fast cells
acid-fast cells stained pink

Kinyoun acid-fast method
modification to acid-fast staining in which the concentration of primary stain, basic fuchsin and phenol are increased, making it unnecessary to heath the cells during the staining procedure
working stock culture
source of inoculum for various tests and stains
Goals to preparing a smear
- adhere the cells to the microscope slide so that they are not washed off during subsequent staining and washing procedures
- it is important to ensure that shrinkage of cells does not occur during staining, or distortion of artifacts can occur
- to prepare thin smears because the thickness of the smear will determine if you can visualize individual cells, their arrangement, or details regarding microstructures associate with cells.
How does smear preparation of cells from liquid medium differ from preparation of cells from a solid medium?
Cells from a liquid medium are placed using a few loopfuls of the broth and cells from a solid medium are smeared in a few drops of water on the slide.
Why is it important to limit the quantity of cells used to prepare a smear?
Too many cells on a slide can obscure the shape and arrangement of the cells as well as inhibit the identification of internal structures.
Describe the potential consequences of making a smear that is too thick.
Stain can become entrapped in the clumps of cells, preventing its removal by destaining and washing and leading to erroneous results for staining reactions


